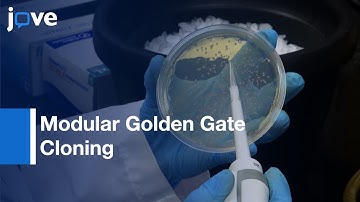
Rapid Assembly Of Multi-Gene Constructs Using Modular Golden Gate Cloning l Protocol Preview

⬇ DOWNLOAD NOW
Kalau muncul iklan pop-up, tutup lalu klik tombol kembali
Download lagu String Assembly gRNA Cloning (STAgR) | Protocol Preview secara gratis hanya untuk keperluan promosi. Dukung artis favorit kamu dengan membeli musik original di iTunes atau platform resmi lainnya.
 Golden Gate Cloning or assembly - Type IIS (BsaI) restriction enzyme based cloning
Golden Gate Cloning or assembly - Type IIS (BsaI) restriction enzyme based cloning
 Introduction to Gibson Assembly
Introduction to Gibson Assembly
 Inside a CRISPR Lab
Inside a CRISPR Lab
 A Detailed Look at Gibson Assembly
A Detailed Look at Gibson Assembly
 CRISPR Explained
CRISPR Explained
 Primer Design and Fragment Assembly Using NEBuilder HiFi DNA Assembly or Gibson Assembly
Primer Design and Fragment Assembly Using NEBuilder HiFi DNA Assembly or Gibson Assembly
Rapid Assembly Of Multi-Gene Constructs Using Modular Golden Gate Cloning l Protocol Preview
Rapid Assembly Of Multi-Gene Constructs Using Modular Golden Gate Cloning l Protocol Preview
 Gibson Assembly Tutorial: Clone Any Gene Fast with NEB Assembly Tool
Gibson Assembly Tutorial: Clone Any Gene Fast with NEB Assembly Tool